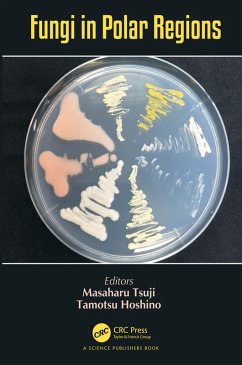

Chemical Fungal Taxonomy (eBook, ePUB)
Versandkostenfrei!
Sofort per Download lieferbar
63,95 €
inkl. MwSt.
Weitere Ausgaben:

PAYBACK Punkte
32 °P sammeln!
Offers comprehensive coverage of the latest developments in both biochemical and physiological approaches to fungal systematics. Incorporates recent advances in molecular biology into systematics methods that can revolutionize taxonomic schemes.
Dieser Download kann aus rechtlichen Gründen nur mit Rechnungsadresse in A, B, BG, CY, CZ, D, DK, EW, E, FIN, F, GR, HR, H, IRL, I, LT, L, LR, M, NL, PL, P, R, S, SLO, SK ausgeliefert werden.